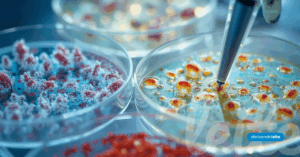

Gestão da Qualidade
Monitoramento Ambiental em Indústrias de Laticínios: Um Guia Prático
Na indústria de laticínios, a qualidade e a segurança dos alimentos dependem diretamente de um conjunto de práticas que vão muito além do processamento do
Na indústria de laticínios, a qualidade e a segurança dos alimentos dependem diretamente de um conjunto de práticas que vão muito além do processamento do